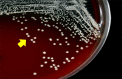

Pleural effusion-related Nocardia otitidiscaviarum, Anaplasma platys and Ehrlichia canis coinfection in a dog
- PMID: 37351788
- PMCID: PMC10484848
- DOI: 10.1007/s42770-023-01029-8
Pleural effusion-related Nocardia otitidiscaviarum, Anaplasma platys and Ehrlichia canis coinfection in a dog
Abstract
The coinfections by some microorganisms have been related to severe diseases in humans and animals, where immunosuppressive agents favor opportunistic behavior of other pathogens. A 4-month-old, female mixed-breed dog with a two-week history of inappetence, prostration, emaciation, and respiratory distress was admitted at a veterinary hospital in Brazil. Tachycardia, pale mucous membranes, severe respiratory distress, and a large number of ticks (Rhipicephalus sanguineus s.l.) in different body regions were observed at clinical examination. Hematological examination of dog showed leukocytosis, neutrophilia, mild anemia, and thrombocytopenia, whereas unremarkable values in biochemical tests. Thoracic radiography revealed a pleural effusion image. Blood and the pleural fluid (purulent aspect) samples were subjected to qPCR (16S rRNA and dsb genes) and sequencing, which identified Ehrlichia canis and Anaplasma platys coinfection. An aggregate of coccoid-to-branching or long filamentous microorganisms, surrounded by pyogranulomatous inflammatory reaction was seen at the cytology of the pleural fluid. Bacteriological culture of pleural effusion showed colonies compatible with the genus Nocardia, which revealed gram-positive filamentous organisms with a tendency of fragmentation and were identified as Nocardia otitidiscaviarum in mass spectrometry (MALDI-TOF MS). Therapy of N. otitidiscaviarum isolate using levofloxacin (supported by a previous in vitro susceptibility testing) and doxycycline for E. canis and A. platys resulted in complete resolution of the clinical picture. Here, we report for the first time a triple coinfection by Nocardia otitidiscaviarum, A. platys, and E. canis in a dog with pleural effusion, where debilitating or immunosuppressive conditions induced by A. platys and E. canis coinfection probably contributed to the opportunistic behavior of N. otitidiscaviarum.
Keywords: Canine cyclic thrombocytopenia; Canine monocytic ehrlichiosis; Canine tick-borne pathogens; Emerging vector-borne pathogens; Nocardiosis.
© 2023. The Author(s) under exclusive licence to Sociedade Brasileira de Microbiologia.
Conflict of interest statement
The authors declare no competing interests.
Figures

References
-
- Dubie T, Mohammed Y, Terefe G, Juhar T. An insight review on canine ehrlichiosis with emphasis on its epidemiology and pathogenicity importance. Global J Vet Med Res. 2014;2:59–60.
MeSH terms
Substances
Supplementary concepts
LinkOut - more resources
Full Text Sources